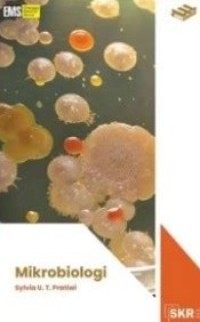
Image of Mikrobiologi

UPA. PERPUSTAKAAN UNIVERSITAS TADULAKO PALU
Pusat Akses Informasi Perpustakaan
Temukan setiap halaman yang menunggu untuk dibaca, setiap pengetahuan yang siap mengubah dunia.
Pusat Akses Informasi Perpustakaan
Temukan setiap halaman yang menunggu untuk dibaca, setiap pengetahuan yang siap mengubah dunia.


Sylvia Utami Tunjung Pratiwi - Nama Orang; Rina Astikawati - Nama Orang; Evie Kemala Dewi - Nama Orang;
Textbook · 2023
Tidak Tersedia Deskripsi
Penanda Bagikan
Tidak tersedia versi lain